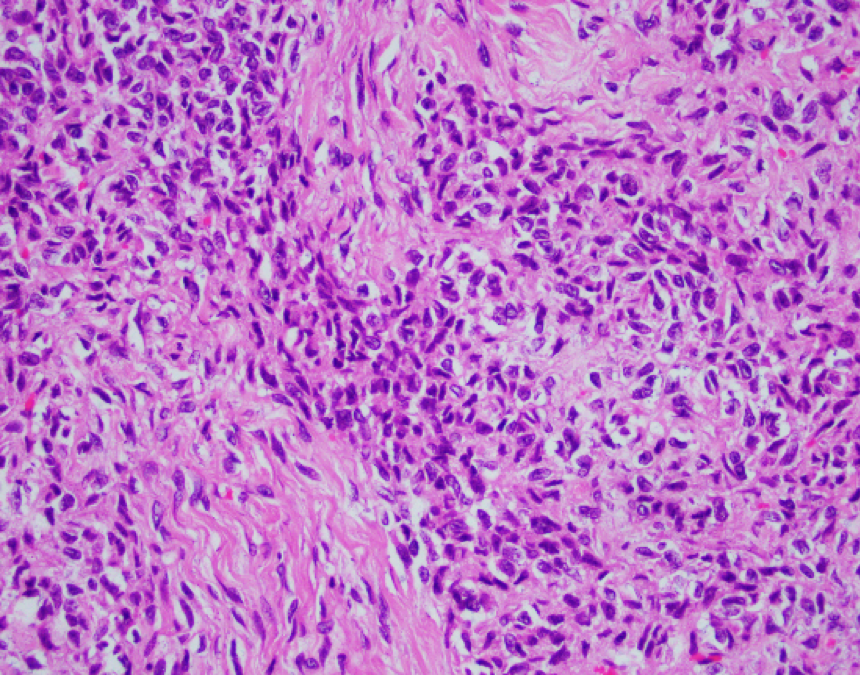
Picture3
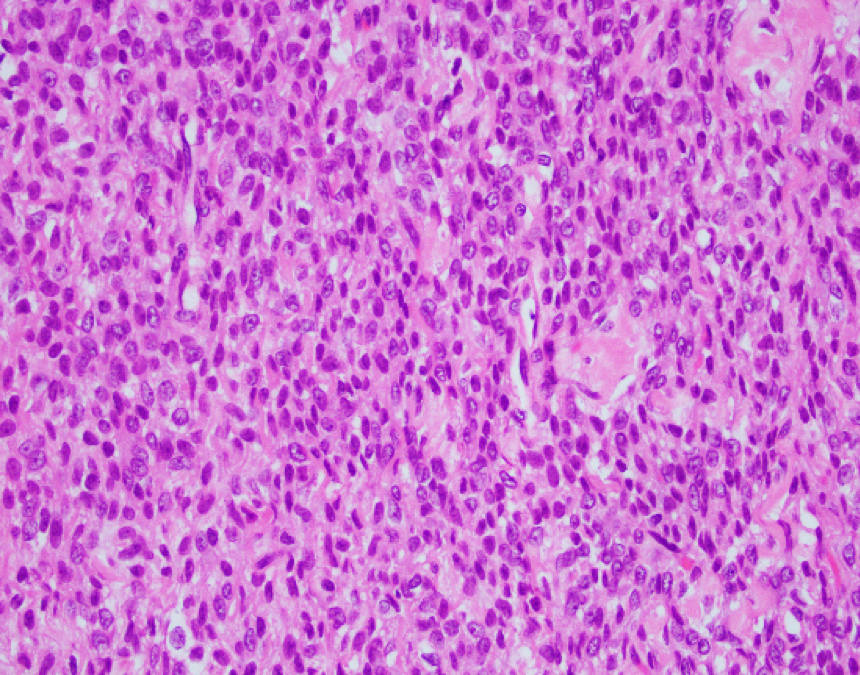
Picture4

Case History
Patient history:
Patient is a 68-year-old female with a about 20 cm ovary mass. The mass has a mixed (solid/cystic) cut surface.
What is the diagnosis?
- A) Acute T cell-mediated rejection.
B) Antibody-mediated rejection.
C) Post-transplant lymphoproliferative disorder.
D) Polyomavirus nephropathy

Answer: C) Post-transplant lymphoproliferative disorder.
This is an adult granulosa cell tumor with areas of edema, necrosis, and calcification. A reticulin stain reveals diminished fibers, encompassing groups of tumor cells. Tumor cells are positive for SF-1 and inhibin, rare cells positive for calretinin, and negative for EMA, and CK7. The morphologic features, special stains, and immunophenotype are those of an adult-type granulosa cell tumor. Small cell carcinoma often has a much high mitotic figure rate, lack of cytological features of AGCT, and inhibin-. AGCT may be occasionally difficult to distinguish from fibromas or fibrosarcomas. Reticulum stains often show abundant intercellular fibrils in these tumors.
Case contributed by: Shoujun Chen, MD, PhD, Instructor & Fellow, Breast/GYN Pathology